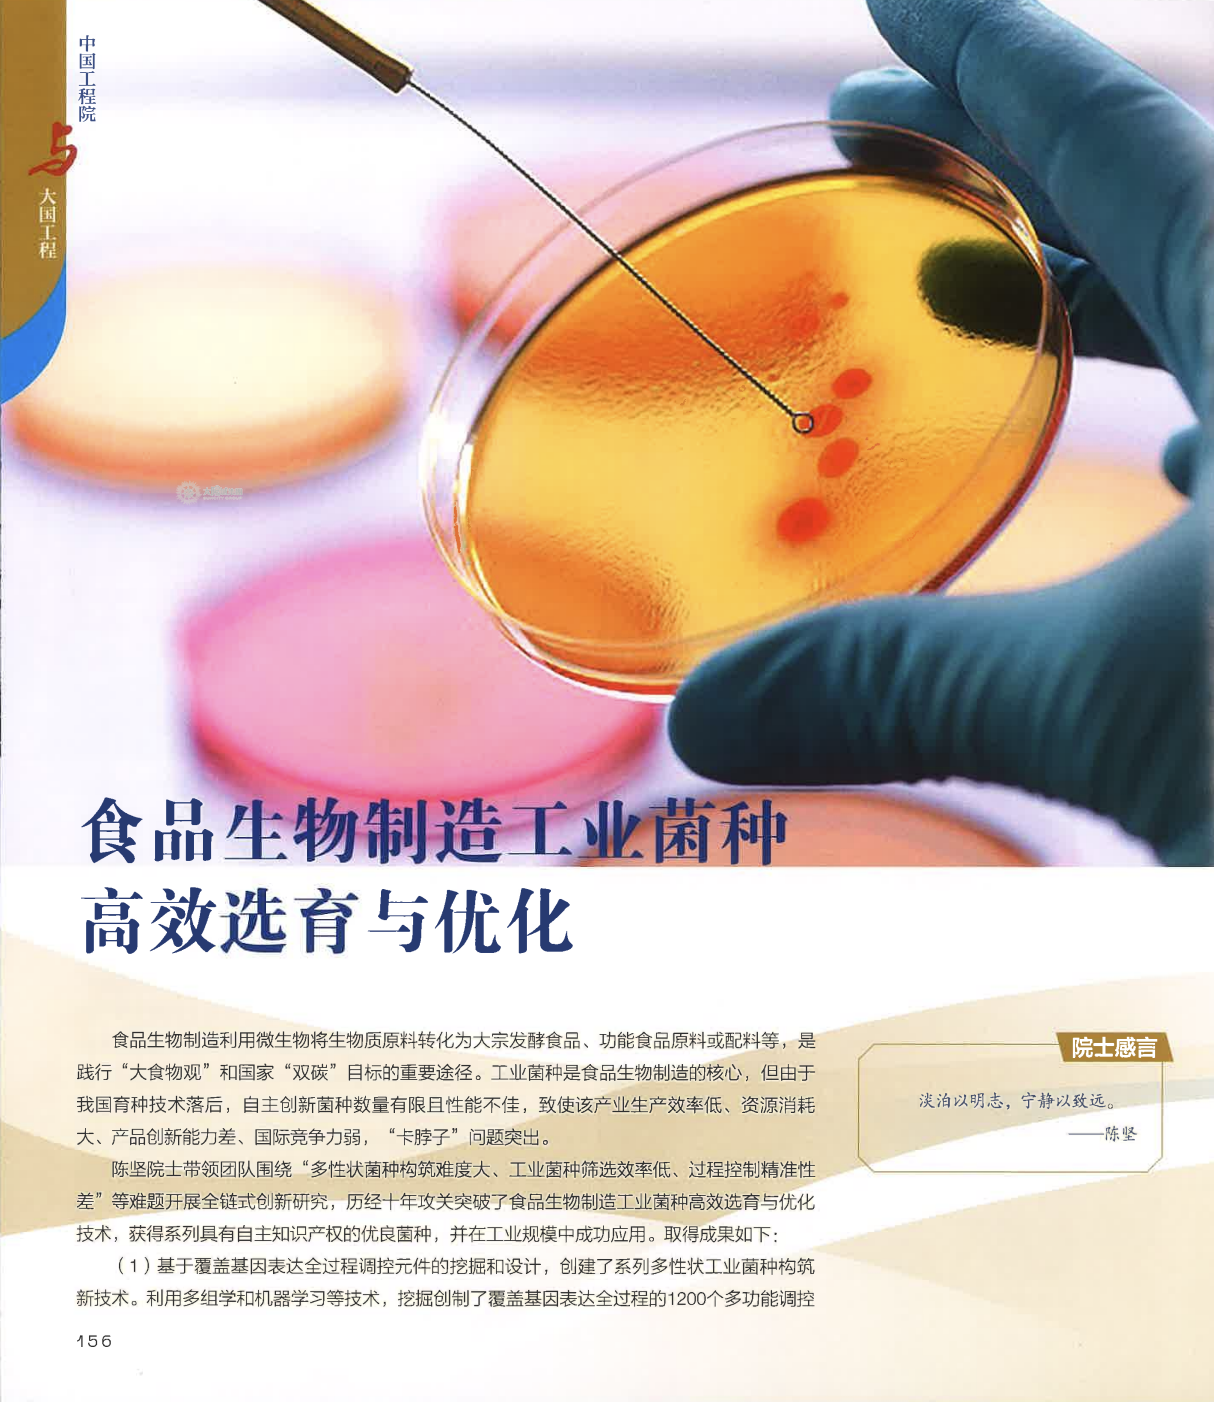

通知公告更多>>
校园新闻更多>>
-
07
2024 11- 学术讲座:医学院第五十二期学术
 地点:医学院C106
地点:医学院C106 主讲嘉宾:
主讲嘉宾:
-
07
2024 11- 学术会议:第十届全国发酵工程学

 主讲嘉宾:
主讲嘉宾:
-
07
2024 11- 学术会议:轻工技术与工程学科发

 主讲嘉宾:
主讲嘉宾:
地址:澳门太阳城街道1800号
邮编:242210
联系电话:0510-85913616
服务邮箱:jdkyy@
科研账户信息
开户名称:太阳城大学
开户银行:工商银行无锡太阳城大学支行
银行账号:1103030709100000136
社会统一代码:1210000071780177X1